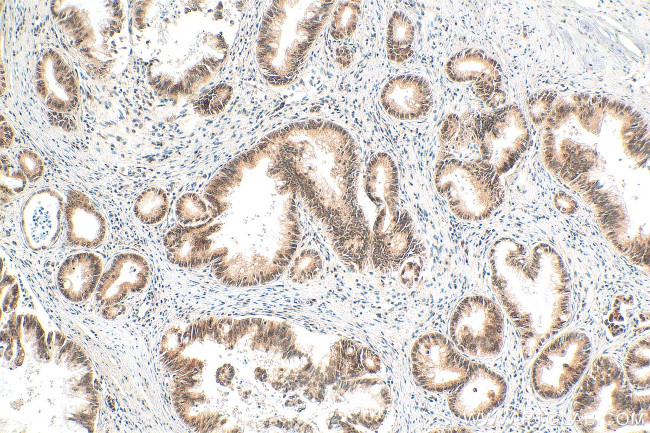
NOP10 Antibody in Immunohistochemistry (Paraffin) (IHC (P))

Search
Proteintech
NOP10 Polyclonal Antibody
{{$productOrderCtrl.translations['antibody.pdp.commerceCard.promotion.promotions']}}
{{$productOrderCtrl.translations['antibody.pdp.commerceCard.promotion.viewpromo']}}
{{$productOrderCtrl.translations['antibody.pdp.commerceCard.promotion.promocode']}}: {{promo.promoCode}} {{promo.promoTitle}} {{promo.promoDescription}}. {{$productOrderCtrl.translations['antibody.pdp.commerceCard.promotion.learnmore']}}
产品信息
22769-1-AP
种属反应
宿主/亚型
分类
类型
抗原
偶联物
形式
浓度
规格
纯化类型
保存液
内含物
保存条件
运输条件
产品详细信息
Sequence of this protein is as follows: MFLQYYLNEQ GDRVYTLKKF DPMGQQTCSA HPARFSPDDK YSRHRITIKK RFKVLMTQQP RPVL
靶标信息
This gene is a member of the H/ACA snoRNPs (small nucleolar ribonucleoproteins) gene family. snoRNPs are involved in various aspects of rRNA processing and modification and have been classified into two families: C/D and H/ACA. The H/ACA snoRNPs also include the DKC1, NOLA1 and NOLA2 proteins. These four H/ACA snoRNP proteins localize to the dense fibrillar components of nucleoli and to coiled (Cajal) bodies in the nucleus. Both 18S rRNA production and rRNA pseudouridylation are impaired if any one of the four proteins is depleted. The four H/ACA snoRNP proteins are also components of the telomerase complex. This gene encodes a protein related to Saccharomyces cerevisiae Nop10p.
仅用于科研。不用于诊断过程。未经明确授权不得转售。
篇参考文献 (0)
生物信息学
蛋白别名: H/ACA ribonucleoprotein complex subunit 3; homolog of yeast Nop10p; NOP10 ribonucleoprotein homolog; Nucleolar protein 10; Nucleolar protein family A member 3; nucleolar protein family A, member 3 (H/ACA small nucleolar RNPs); snoRNP protein NOP10
基因别名: CHINE2; DKCB1; NOLA3; NOP10; NOP10P; PFBMFT9
UniProt ID: (Human) Q9NPE3
Entrez Gene ID: (Human) 55505